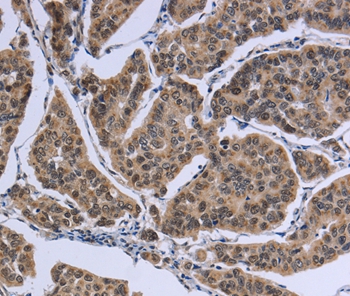

Goat anti-RANBP8 / IPO8
EB05535
ApplicationsELISA, ImmunoHistoChemistry
Product group Antibodies
ReactivityBovine, Canine, Human, Porcine
TargetIPO8
Overview
- SupplierEverest Biotech
- Product NameGoat anti-RANBP8 / IPO8
- Delivery Days Customer5
- ApplicationsELISA, ImmunoHistoChemistry
- Applications SupplierPep-ELISA, IHC
- CertificationResearch Use Only
- ClonalityPolyclonal
- Concentration0.5 mg/ml
- Gene ID10526
- Target nameIPO8
- Target descriptionimportin 8
- Target synonymsRANBP8, VISS, importin-8, RAN binding protein 8, imp8, ran-binding protein 8
- HostGoat
- Scientific DescriptionRefSeq number(s): NP_006381.2; NP_001177924.1. Purification: Antigen affinity purified. Names and symbols: IPO8; importin 8; RANBP8; RAN-binding protein 8; FLJ26580; RAN binding protein 8
- ReactivityBovine, Canine, Human, Porcine
- Reactivity SupplierHuman, Dog, Pig, Cow
- Storage Instruction-20°C
- UNSPSC12352203